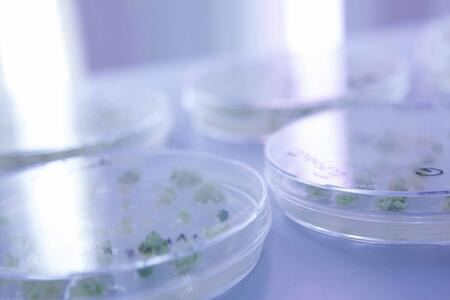

Meilensteine
-

1984
Gründung der Saaten-Union Resistenzlabor oHG durch die sieben Gesellschafter der Saaten-Union GmbH. 1984 wird in Leopoldshöhe-Hovedissen auf der Zuchtstation W. von Borries-Eckendorf mit den ersten Laborarbeiten begonnen. Etablierung der Gewebekultur (Gerstenantherenkultur, Rapsmikrosporenkultur).
-

1985
Seit 1985 wird die Doppelhaploiden-Technik (DH-Technik) im Labor angewendet, um Resistenzen und andere Zuchtmerkmale bei Gerste, Raps, Weizen und Triticale schneller und effektiver zu selektieren.
-

1992
Durchflusscytometrie (DFLC): Mit Hilfe einer speziellen Methode kann der Ploidiegrad einer Pflanze bestimmt werden. So können die Doppelhaploiden (DH) selektiert werden.
-

1993-1996
Nach der Etablierung von Resistenztestungen und Technologien für die Erstellung von doppelhaploiden Linien bei Gerste, Raps, Roggen, Weizen, Triticale und Durumweizen wird 1996 das Markerlabor ausgebaut. Durch die Verwendung molekularer Marker werden den Züchtern schnell sichere Daten über die Genetik ihrer Linien an die Hand gegeben.
-

1998
Entwicklung des CrushExpress zur Zerkleinerung von Pflanzenmaterial für die Verwendung bei der DFLC, Gebrauchsmusterschutz in 1999. Mit dem CrushExpress können simultan 96 Proben aus festen Materialien (Pflanzenteile, Samen, Lebensmittelproben...) zerkleinert und/oder extrahiert werden. Das kann in handelsüblichen 96er Deep Well Platten geschehen.
-
1999-2000
Im Jahr 1999 Beitritt der DSV (Deutsche Saatveredelung AG) als achter Gesellschafter. Das BMBF fördert das Projekt NAPUS 2000, daraufhin wird bei Saaten-Union Biotec das Transformationslabor ausgebaut.
-

2004
Errichtung eines neuen Abschnittes der Gewächshausanlage.
-

2006
Bau und Eröffnung der zweiten Betriebsstätte im Biopark Gatersleben zur Kapazitätsausweitung.
-

2009
Am 27. April 2009 wird im Rahmen einer Vortragsveranstaltung das 25-jährige Bestehen der Firma gefeiert. Züchtern, Wissenschaftlern und Vertretern aus Politik und Presse wird die eindrucksvolle Entwicklung des Labors, die Zusammenarbeit mit den angeschlossenen Zuchtbetrieben und der Erfolg der in der Praxis angebauten Sorten präsentiert. Gleichzeitig wird die Umfirmierung in Saaten-Union Biotec GmbH auf Grund der international ausgerichteten F&E Projekte bekanntgegeben.
-

2010
Erneut steht eine Erweiterung der Gewächshäuser an, um dem erhöhten Bedarf gerecht zu werden. Zu diesem Zeitpunkt sind über 40 Mitarbeiterinnen und Mitarbeiter bei der Saaten-Union Biotec GmbH beschäftigt.
-

2011-2012
Im Jahr 2011: Beitritt der Solana Research GmbH als neunter Gesellschafter. Im Jahr 2012 Vollendung des Ausbaus der Gewächshäuser.
-

2015
Mittlerweile sind über 75 Mitarbeiter bei Saaten-Union Biotec beschäftigt. Ein wissenschaftlicher Schwerpunkt liegt im Bereich der neuen Züchtungstechniken.
-

2017
Neues Logo, gleichbleibend gute Qualität
-

2018
Erweiterung der Kühlraumkapazitäten
-

2019
Modernisierung der Laborräume in Hovedissen
-

2022
Langfristige Sicherung des Standortes Gatersleben. Durch den Erwerb des Laborgebäudes wurden die räumlichen Kapazitäten deutlich ausgebaut.
-

1984
-

1985
-

1992
-

1993-1996
-

1998
-

1999-2000
-

2004
-

2006
-

2009
-

2010
-

2011-2012
-

2015
-

2017
-

2018
-

2019
-

2022


